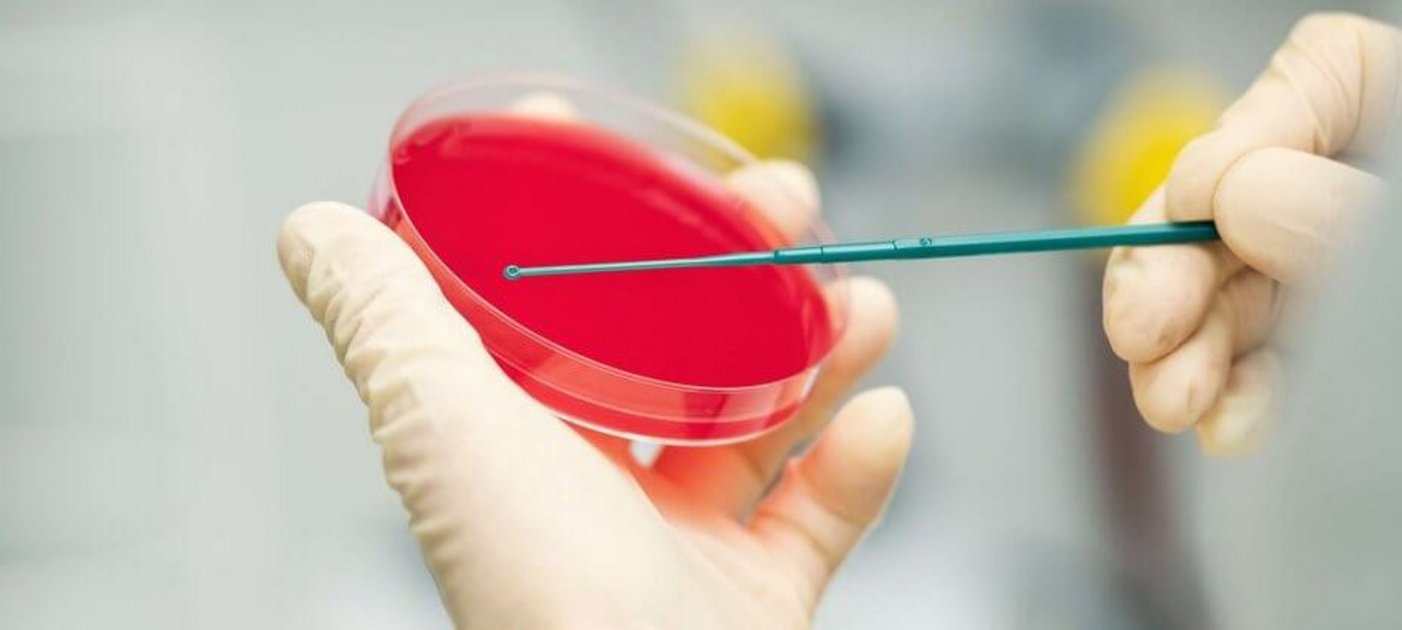

Head of Unit for Food Microbiology
Univ.-Prof. Dr.med.vet. Martin Wagner, Dipl.ECVPH
T
+43 1 25077-3500
E-Mail
Deputy head
Dr.med.vet. Beatrix Stessl
T
+43 1 25077-3502
E-Mail
Research Projects
| BIMM | BIMM-Bioactive Microbial Metabolites |
| FFoQSI | Austrian Competence Centre for Feed and Food Quality, Safety & Innovation |
| Microbiom Support | Microbiom Support |
| MASTER | MASTER |
| FWF Projekt | Hypervariable genetische Hotspots in Listeria monocytogenes |
| AMICI | Austrian Microbiome Initiative |